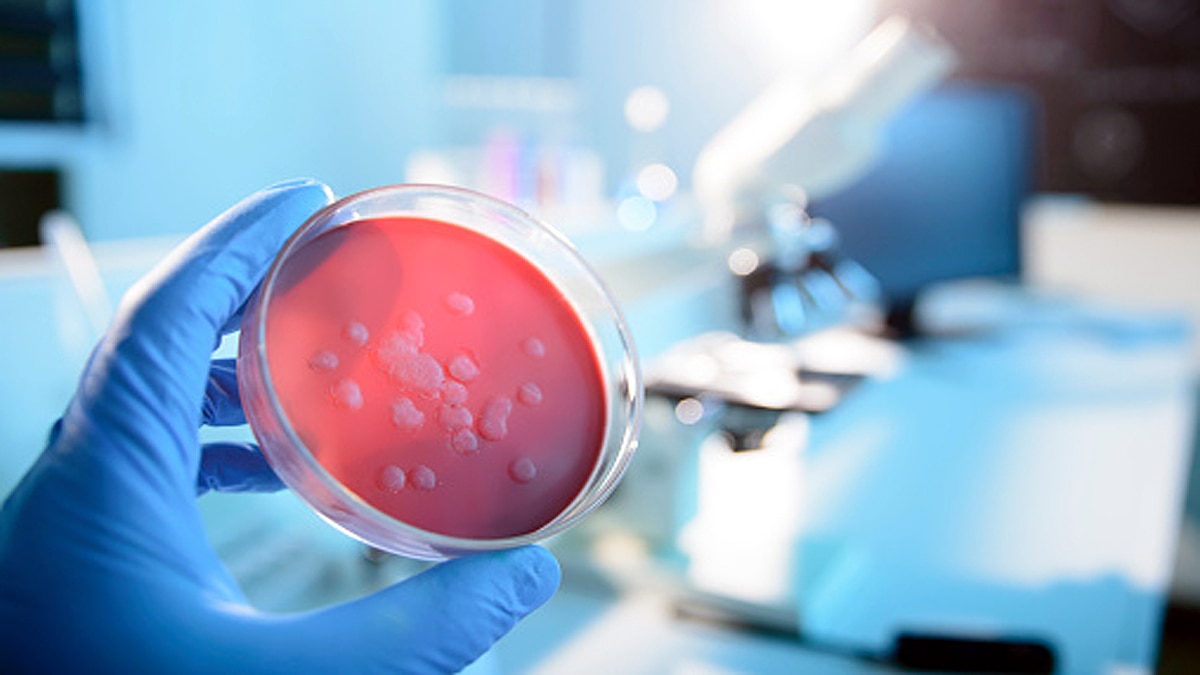
Ebola Lingered in Survivor for 5 years

इबोला वायरस पांच साल तक इंसानी शरीर में छिपा रहा, अब फैला रहा नया संक्रमण
इबोला महामारी अभी अफ्रीकी देशों से खत्म नहीं हुई है. 2014 के पांच साल बाद अचानक फिर साल 2019 में इसका नया आउटब्रेक शुरू हो गया. वैज्ञानिकों का मानना है कि वायरस 2014 से 2016 तक लोगों को बीमार करने के बाद कुछ ऐसे इंसानों के शरीर में निष्क्रिय होकर छिप गया. बाद में जब उपयुक्त माहौल मिला तो वह फिर अपना संक्रमण फैलाने लगा. अब यही संक्रमण पश्चिमी अफ्रीकी देश गिनी में फैल रहा है. (फोटोःगेटी)
वैज्ञानिक ये बात पहले से जानते थे कि इबोला वायरस किसी के शरीर में छिपा हो सकता है. खासकर शरीर के उन भागों में जहां प्रतिरक्षा प्रणाली कमजोर है जैसे कि आंख, अंडकोष आदि. इसका मतलब ये है कि व्यक्ति घातक संक्रमण से उबरने के बाद भी कुछ समय तक वायरस का प्रसार कर सकता है. दुर्लभ स्थिति में ये किसी दूसरे व्यक्ति को भी संक्रमित कर सकता है. अब तक इबोला वायरस का सबसे लंबा संक्रमण 500 दिनों बाद देखा गया है. (फोटोःगेटी)
एक नए विश्लेषण से पता चला है कि इबोला वायरस न केवल लंबे समय तक छिप सकता है बल्कि इसमें नए संक्रमण को फैलाने की भी क्षमता होती है. गिनी (Guinea) में हाल ही में हुए इबोला आउटब्रेक में 18 लोग संक्रमित हुए. 9 लोगों की जान चली गई. गिनी के स्वास्थ्य मंत्रालय ने हाल ही में संक्रमण के 3 नमूनों को वर्ल्ड हेल्थ आर्गेनाइजेशन की लैबोरेटरी में जांच के लिए भेजा है. (फोटोःगेटी)
यहां रिसर्चर्स ने सैंपल की जीनोम सिक्वेंसिंग की और पता लगाया कि वो कौन से जीन हैं जो फिर से संक्रामक जीनोम बना रहे है? इसके बाद इन नए नमूनों की पुराने सैंपल्स से तुलना की गई. तब पता लगा कि नया वैरिएंट 2014 में फैले मकोना वैरिएंट से मिलता-जुलता है. इसने 2014 से 2016 के बीच पश्चिम अफ्रीका में संक्रमण फैलाया था. इसकी वजह से गिनी, लाइबेरिया, सिएरा लियोन के 11 हज़ार लोगों की जान गई थी. (फोटोःगेटी)
रिसर्चर ने virological.org पर प्रकाशित विश्लेषण में लिखा है कि नए वैरिएंट में केवल एक दर्जन अनुवांशिक अंतर थे. एक थ्योरी ये कहती है कि पश्चिम अफ्रीका में आउटब्रेक के बाद वायरस चुपचाप पर्सन-टू-पर्सन फैल रहा था. जो कि पिछले पांच वर्षों में 100 अलग-अलग म्यूटेशन से विकसित हुआ होगा. इसके बजाय ज्यादा संभावना इस बात की है कि वायरस 5 साल पहले पिछले आउटब्रेक के दौरान किसी संक्रमित व्यक्ति के शरीर में पड़ा होगा. ये सेक्सुअल ट्रांसमिशन के जरिए किसी दूसरे के शरीर में आया है, जिससे वर्तमान में फिर संक्रमण फैला. (फोटोःगेटी)
वायरस बॉडी में घूम सकता है. दुर्लभ परिस्थिति में ही किसी और को संक्रमित कर सकता है. इस तरह के संक्रमण तब होते हैं जब किसी पुरुष को संक्रमण हो और शारीरिक संबंध के जरिए वो संक्रमण किसी महिला के शरीर में पहुंच जाए. (फोटोःगेटी)
Ebola may have lingered in a survivor for 5 years before sparking new outbreak https://t.co/vDHgcDdPm4 pic.twitter.com/xeIOUtQeZn
— Live Science (@LiveScience) March 16, 2021
साइंस मैगजीन के अनुसार इस नए आउटब्रेक के केस में कहानी अब भी गड़बड़ है. अभी और रिसर्च की जरूरत है कि वाकई में हुआ क्या था. गिनी में जो आउटब्रेक का पहला केस सामने आया वो एक नर्स थी जो संक्रमित थी. इस साल जनवरी में उसकी मौत हो गई. हालांकि यह भी संभव है कि नर्स अपनी बीमार मां की देखभाल करते हुए संक्रमित हुई हो. इसके बाद कुछ संक्रमण के केस आए और जो लोग संक्रमित थे, वो लोग नर्स के अंतिम संस्कार में गए थे. (फोटोःगेटी)
इस विश्लेषण से पहले वैज्ञनिकों ने माना था कि नए इबोला का आउटब्रेक ज्यादातर जानवर की प्रजातियों से मानव में आने वाले वायरस से हुआ है. ये संभव है कि गिनी में ऐसा ही हुआ हो. लेकिन ये पूरी तरह सही नहीं हो सकता क्योंकि पुराने वैरिएंट और नए वैरिएंट काफी मिलते-जुलते थे. न्यूयॉर्क टाइम्स के अनुसार निष्कर्ष से यह भी सवाल उठता है कि क्या संक्रमित जानवरों की बजाय जीवित बचे लोग अफ्रीका में आउटब्रेक को जन्म दे सकते हैं. (फोटोःगेटी)
Virological.org पर रिसर्चर की एक पोस्ट के अनुसार इबोला 5 साल पहले के संक्रमित व्यक्ति से वापस जीवित हो गया हो. लेकिन ये सर्वाइवर के लिए परिवार, कम्युनिटी के लिए और हेल्थ सिस्टम के लिए एक नया चैलेंज खोलता है. जिसको कम्युनिटी के साथ और ज्ञात, अज्ञात सर्वाइवर के साथ काम करने के तरीके खोजने चाहिए, बिना लोगों को दोषी ठहराए. (फोटोःगेटी)